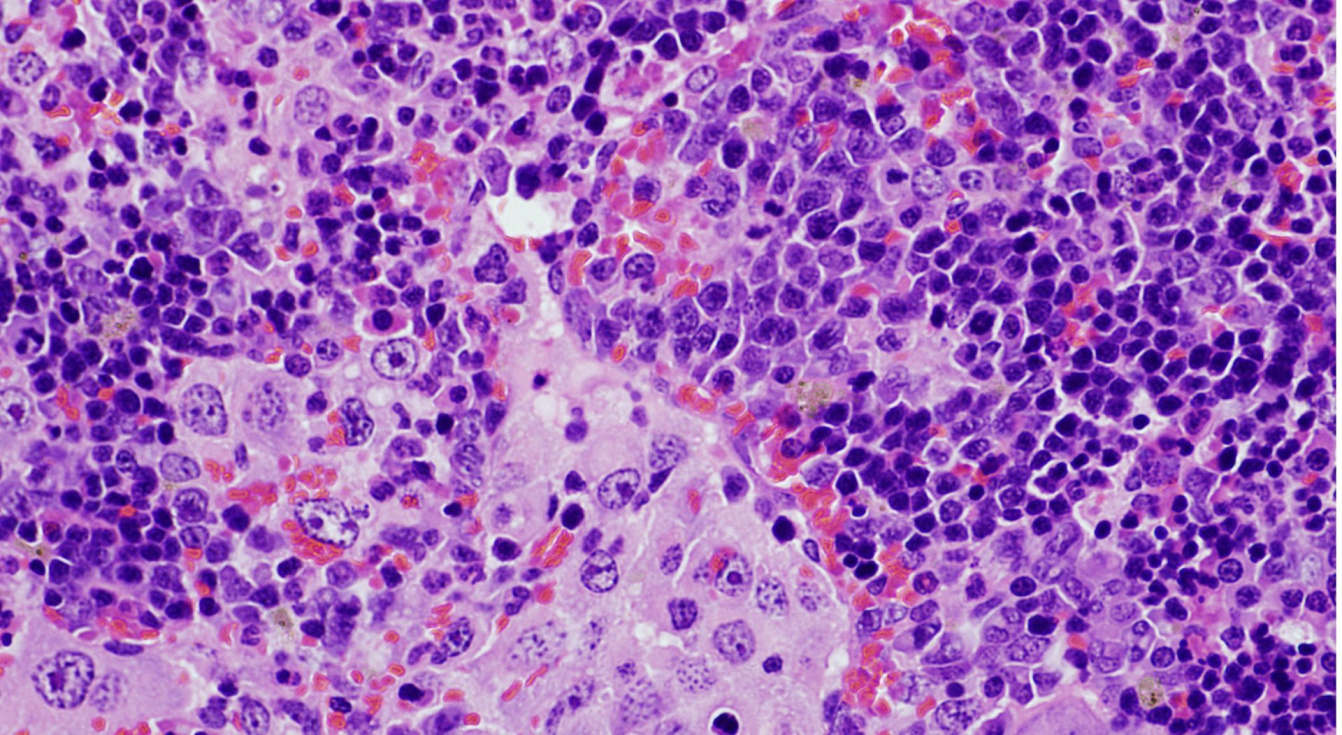

Un equipo de investigación liderado por el Consejo Superior de Investigaciones Científicas (CSIC) ha identificado que una alteración genética que afecta al gen VAV1 desempeña un importante papel en tumores derivados de los linfocitos T (linfomas) y el cáncer de pulmón, dos tipos de cánceres que se caracterizan por tener tasas de supervivencia muy bajas. El grupo de investigación que ha realizado este estudio, que está formado por científicos del Centro de Investigación del Cáncer (CSIC-USAL), centro mixto del CSIC y la Universidad de Salamanca, y el Centro de Investigación Biomédica en Red de Cáncer (CIBERONC), ha descubierto también que esta alteración genética desempeña funciones pro-tumorales diferentes dependiendo del tipo de órgano en el que surge. El trabajo se publica en la revista Molecular Oncology.
“Los estudios recientes de secuenciación del genoma de un amplio número de tumores han revelado que estos albergan miles de alteraciones genéticas, las denominadas mutaciones. Esto ha creado un nuevo problema: saber cuáles son importantes para el desarrollo del cáncer o la adquisición de sus propiedades malignas, si lo son de forma autónoma o necesitan otras alteraciones genéticas simultáneamente y si se pueden identificar vulnerabilidades asociadas a estas alteraciones genéticas que permitan desarrollar nuevas terapias anti-tumorales”, explica Xosé R. Bustelo, que lidera este trabajo y es investigador en el CIC (CSIC-USAL).
La mayoría de estas alteraciones genéticas tienen efectos neutros en las células tumorales y, por tanto, no provocan el desarrollo o la progresión maligna de los tumores que los albergan. Pero muchas de las alteraciones genéticas que sí tienen un papel relevante en cáncer se encuentran a muy baja frecuencia en los pacientes y, como consecuencia, su identificación es compleja. Según señalan los investigadores del estudio, esto continúa siendo un gran reto científico.
“El gen VAV1 se detectaba en tumores derivados de células que, como los linfocitos T (responsables de nuestras respuestas inmunes), sí expresaban de forma normal este gen. Sin embargo, también se detectaba en algunos tumores que, como en el cáncer de pulmón, derivaban de células que normalmente no expresaban esta proteína. Esto nos hizo preguntarnos si esta alteración genética era importante en ambos casos y, en dicho caso, intentar conocer los mecanismos que influencian el desarrollo de estos tumores”, apunta Javier Robles-Valero, científico del CIC (CSIC-USAL) y el Centro de Investigación Biomédica en Red (CIBERONC) y primer autor de este trabajo.
Otros genes implicados
El trabajo muestra que el espectro de tumores generados depende de la presencia de alteraciones genéticas en otros dos genes distintos (TRP53 y KRAS). A partir de un modelo de ratón modificado genéticamente que contenía la alteración en el gen VAV1, los investigadores han podido determinar el papel de este gen en varios tipos de cáncer. “Por un lado, hemos demostrado que la alteración genética en VAV1 no es suficiente para inducir la formación de tumores en ningún órgano de los ratones. Sin embargo, cuando se combina con la eliminación del gen antitumoral TRP53 provoca el rápido desarrollo de un tumor muy específico de linfocitos T conocido con el nombre de linfoma periférico de células T. Pero no se han detectado otros tipos tumorales, indicando que la combinación de estas dos alteraciones genéticas solo da lugar a un tipo de tumor”, señala Robles-Valero.
En el caso del cáncer de pulmón, los investigadores decidieron comprobar si las mutaciones de VAV1 necesitan el concurso de alteraciones genéticas en otros genes ya que los ratones que poseen alteraciones genéticas que activaban los genes VAV1 y al gen pro-tumorigénico KRAS sí desarrollan tumores de pulmón. “Probablemente se debe a que, a diferencia de la eliminación del gen TP53, la activación del gen KRAS conlleva la expresión de VAV1 en células de pulmón que, en condiciones normales, nunca expresan este último gen”, indica Bustelo.
Estos modelos animales “servirán de base para seguir estudiando el desarrollo progresivo de los dos tipos de tumores y, sobre todo, para ensayar nuevos fármacos frente a ellos, ya que los resultados que aporta este trabajo han permitido identificar dianas terapéuticas potenciales para acabar los tumores que poseen las alteraciones genéticas en el gen VAV1”, concluye Robles-Valero.
Referencia científica:
Javier Robles-Valero; Lucía Fernández-Nevado; Myriam Cuadrado; Luis Francisco Lorenzo-Martín; Isabel Fernández-Pisonero; Antonio Abad; Esther Redín; Luis Montuenga; Dionisio Martín-Zanca; Anna Bigas; Moisés Mallo; Mercedes Dosil y Xosé R Bustelo. Characterization of the spectrum of trivalent VAV1-mutation-driven tumours using a gene-edited mouse model. Molecular Oncology. DOI: 10.1002/1878-0261.13295

Normas de participación
Esta es la opinión de los lectores, no la de este medio.
Nos reservamos el derecho a eliminar los comentarios inapropiados.
La participación implica que ha leído y acepta las Normas de Participación y Política de Privacidad
Normas de Participación
Política de privacidad
Por seguridad guardamos tu IP
216.73.216.222